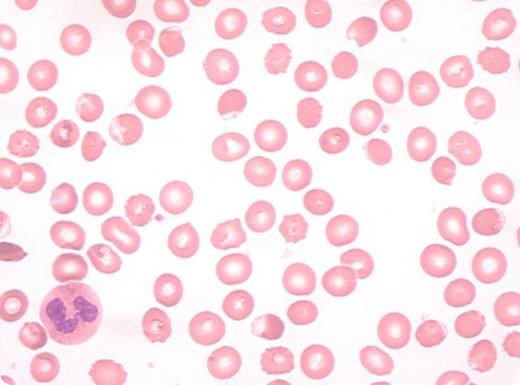
red cell film that shows a patient with a case of favism. / Red cell film from a patient with a case of favism.

red cell film that shows a patient with a case of favism
Red cell film from a patient with a case of favism.
Red cell film from a patient with a case of favism.
Pythagoras, who I believe was also somewhat accomplished in mathematics, was the first person to record that the ingestion of fava beans could be dangerous. However, his claim is qualified with magnificent equipoise in this sublime review by Drs. Lucio Luzzatto and Paolo Arese: “This gives him a place in nutrition science but not in nutrigenomics: it seems he did not realize that the danger depended on the genotype of the person eating the beans.”
Living, as we are, in a time in which the exact date of online publications is often scrutinized, Pythagoras could at least console himself with the knowledge that he was 2,500 years ahead of his peers.
It is now 62 years since glucose-6-phosphate dehydrogenase (G6PD) deficiency was discovered in people who experienced hemolytic crises following ingestion of the antimalarial primaquine in 1956. This review, which focuses on one of the three syndromes of G6PD deficiency (the others being neonatal jaundice and drug-induced hemolytic anemia) reveals how favism continues to hold a place as an exemplar of personalized medicine.
As the authors state, “In favism, there are two main actors: the bean and the red cell.” Fava beans and genetic susceptibility must come together to elicit the outcome of favism. Ironically, the fava bean plant (Vicia faba; known to many as the broad bean) may have been the first plant to be domestically cultivated and produces a protein-rich bean that can be eaten hot or cold. The problem is that the bean’s protein content can include as much as 2 percent vicine and convicine, which are converted in the gut to divicine and isouramil. These highly redox proteins are likely to retard rotting of the bean, but produce reactive oxygen species (ROS) including the superoxide anion and hydrogen peroxide, which rapidly oxidize NADPH and glutathione. These molecules are normally detoxified by catalase and glutathione peroxidase, in enzymatic reactions that depend on NADPH. Because NADPH levels are very low in G6PD-deficient red cells, these undergo severe oxidative damage. A characteristic feature of favism is that intracellular and extracellular hemolysis coexist. The intracellular damage is easy to explain, whereas extracellular hemolysis occurs as complement is fixed on the cell and triggers phagocytosis.
More than 200 different genetic mutations are known to cause G6PD deficiency and most of them probably can elicit favism. The gene is present on the X chromosome, so boys are more commonly affected than girls, though random X inactivation in heterozygous females can also lead to their susceptibility. The complete loss of G6PD function is lethal, so all mutations retain varying degrees of enzymatic activity. G6PD mutations are one of the myriad genetic legacies of the tectonic forces of evolutionary selection mediated by malarial infection on the human genome. Heterozygous levels of G6PD offer relative protection against parasite carriage but this benefit to the population has come at the expense of considerable morbidity and mortality for millions of people. Indeed, favism remains probably the most common cause of acute hemolytic anemia.
Robert Heinz described the supravital stain to detect his “bodies” in blood smears back in 1890, but it remains a valuable test to visualize oxidized hemoglobin fragments. “This test takes time and must be performed by a competent hematologic technologist,” according to Drs. Luzzatto and Arese, “but it does not require expensive equipment or reagents; the test is unlikely to be performed nowadays.” Additional tests of importance are a blood count and a blood film, which will demonstrate the remnants of the battlefield of oxidative damage on red cells. Classic features include “hemighosts” and “blister cells,” as well as the spherocytes and dense red cells that are at an earlier stage of damage. The urine is dark and full of hemoglobin, and the level of unconjugated bilirubin in the serum is very high. “The parents, if asked, almost always report that their son has dark urine and has eaten fava beans.”
A well-described case history brings a topic alive as the authors describe the typical scenario of a boy aged two to 10 years, with acute fatigue, pallor, and abdominal pain. Intracellular hemolysis is apparent from the dark urine and abdominal symptoms resulting, as in paroxysmal nocturnal hemoglobinuria, from the consumption of nitric oxide from free hemoglobin. Jaundice and splenomegaly are features of the extracellular contribution of red cell destruction.
“Once a diagnosis of favism has been made, management is usually not difficult,” the authors assure us. The biochemistry is challenging, but the treatment, for once, is straightforward. Mild cases may need only hydration and symptomatic treatment, but for others, blood transfusion is required and is rapidly effective. Transfusion should be given where hemoglobin concentration is lower than 70 g/L and at a higher threshold if there is brisk hemolysis.
Red cell biology has led in many areas of medical science, and this is not a review that rests in the past. The future looks toward elimination of the burden of favism. One approach is through neonatal screening and appropriate risk management. A population-based solution would be to introduce natural or genetically engineered plants which are selected for low production of vicine. “At a time when most countries declare that preventive medicine is a priority, the seeds from the low vicine cultivars ... ought to be distributed ... in all areas where fava beans are popular,” the authors conclude.
In Brief
This is a review that deserves to be read by all hematologists. With knowledge, wisdom, and compassion the authors chart the remarkable progress in understanding the pathogenesis and potential eradication of this disorder. In an era dominated by “personalized medicine,” these reflections remind us of how long this has been at the center of hematology practice and how we can guide others along this path.
Competing Interests
Dr. Moss indicated no relevant conflicts of interest.